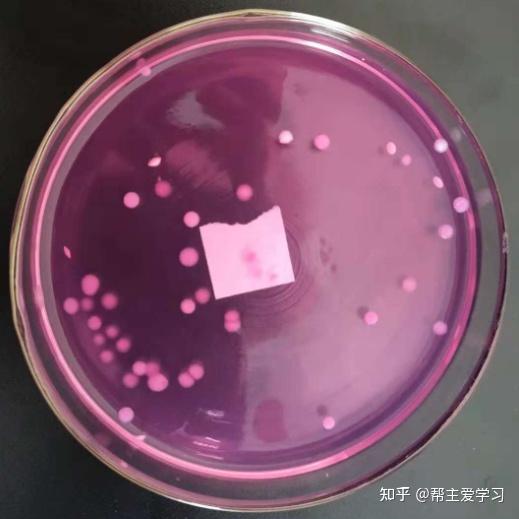
用灭菌吸管吸取 1:10 稀释的检液 2ml,分别注入到两个灭菌平皿内,每皿

菌帮主活性菌

哆力星球益生菌帮主子告别玻璃胃
图片尺寸1080x809
菌帮主金针菇红油香辣味小包装开袋即食下饭菜解馋开胃休闲小零食
图片尺寸800x800
大家都在搜: 乔帮主(乔锋) 粉丝 1213 获赞 769 关注 云南野生菌精挑
图片尺寸800x800
菌帮主川香金针菇【30克】
图片尺寸400x420
菌帮主新鲜香脆金针菇宿舍办公看剧零食速食爽口嫩滑小零食下饭菜 川
图片尺寸800x800
菌帮主金针菇红油香辣味小包装开袋即食下饭菜解馋开胃休闲小零食
图片尺寸800x800
菌帮主香辣金针菇小包装开袋即食下饭菜麻辣休闲小零食小吃下饭菜金针
图片尺寸800x800
菌帮主金针菇小包装香辣红油开袋即食下饭菜麻辣素食休闲零食小吃
图片尺寸800x800
不用着急,帮主这回将带上几位小"伙伴"一起去到盛产菌子的南华,易门和
图片尺寸640x416
淘宝返利机器人优惠少女帮主分享
图片尺寸360x360
野生菌子居然能卖到五六十元一斤,农村大妈们都半夜起来去山里捡
图片尺寸578x642
帮主趣生活超话#小众宝藏旅行地##北京旅行#今天我们都是巴奴"干饭人"
图片尺寸690x1035
海淘帮帮主
图片尺寸360x361
请问能够通过活性菌的冻干粉来复苏得到细菌吗? - 知乎
图片尺寸528x423
用灭菌吸管吸取 1:10 稀释的检液 2ml,分别注入到两个灭菌平皿内,每皿
图片尺寸519x519
乔帮主聊蔬菜(菌崔莱)的快手直播
图片尺寸720x1280
今天还是野生菌火锅.帮主说这样照相她显瘦.09雨中勤工俭学的孩子.
图片尺寸750x1333
吃货在这里##帮主晒单
图片尺寸690x460
乔帮主是个小吃货上传的图片
图片尺寸700x467
自己制作生物菌肥,不用花钱肥效还好!_白水县农村信息网_农村链
图片尺寸640x884